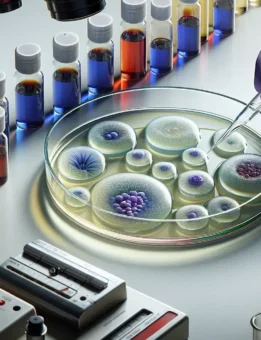

Biotecnología aplicada al control de micotoxinas en sistemas porcinos.
Autora: MV María Fernanda Jabif. Depto Técnico Vetanco Argentina El desafío de controlar las micotoxinas en los sistemas de producción animal es creciente. En particular el cerdo, su alta sensibilidad a la mayoría de las micotoxinas presentes en las materias primas, exige que se desarrollen soluciones eficaces para controlar el impacto productivo porcino. Panorama general […]Leer más


